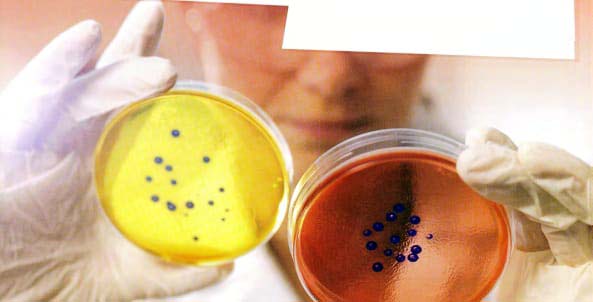

Antibiotics have been one of humanity's success stories for hundreds of years, being responsible both for saving the lives of millions of patients and for helping scientists to take enormous steps in the fields of medical and surgical treatment. But this success has come at a price. The growing resistance of many bacterial strains to the curative effects of antibiotics is such a concern that it has been referred to, in some quarters, as the greatest threat to our continued existence on earth. We have become careless, it is argued, not only in our reliance on the quick fix of medicine if we feel even slightly under the weather, but also in taking the availability of antibiotics for granted, using them incorrectly, not following the prescribed dosage. This has given rise to a new form of super bacteria, a type which is able to fight off antibiotic treatment with ease.
Although their resistance to antibiotics has been built up over a long period of time, bacteria actually replicate extraordinarily quickly, and any resistance developed is also duplicated as they divide. In addition, those bacteria carrying resistance genes happen to spread those genes further via 'horizontal gene transfer', a process whereby one bacterium passes on the resistance gene from another without even needing to be its parent. What makes the spread of these strains more difficult to control is that it occurs in a cyclical process. In the case of humans, when a person becomes infected and the resistant bacteria set up home in the gut, the sufferer has two choices: look for help or stay at home. In seeking medical assistance, whether through an appointment to visit their local doctor, or taking themselves to hospital, they contaminate other patients, later to be discharged and sent home. The resistant bacteria then spread out into the local community. This is also the end result if the infected person decides not to seek any medical assistance at all: they keep the bacteria at home and allow them to breed without treatment.
Livestock also play their part in dispersing these newly evolved, bullet-proof microorganisms into the food chain. These resilient bacteria do not discriminate between man and beast, and so animals play host to the very same bacteria as are found in humans, with the end result that our farms and abattoirs have become breeding grounds for inter-species infection. In fact, even after slaughter, these bacteria can easily survive on animal carcasses, remaining alive and reproducing until the point of purchase and beyond, eventually invading our systems when we ingest the flesh as infected meat. So is the answer simply to become a vegetarian? Sadly not. The very same resistant bacteria will leave a host animal's gut in the form of faeces, which are employed in agriculture as manure to support food crops. From there, the wheat, maize and corn that are grown for human consumption transport the bacteria into our bodies. There really is no escape.
That said, there is always something that can be done to try and minimise any risk, however much of a lost cause it might seem. In 2014, after accumulating data from 114 countries, the World Health Organization (WHO), issued a set of guidelines intended to tackle the increasing problem of resistance. Doctors and pharmacists were advised to avoid prescribing and dispensing antibiotics as much and as often as possible. Only when treatment is utterly necessary should they resort to doing so, while the greatest of care should be taken to ensure that the antibiotics they provide are the correct ones to treat the illness. In turn, the general public must play their part by only taking antibiotics as prescribed by a doctor, as well as making sure they see out the full course, even if they feel better before the antibiotics are finished. Additionally, they should never share their medication with others or - astonishing as it may seem that this would need to be stated - buy drugs online.
Away from the individual and onto organisations, the WHO has urged policymakers to invest in laboratory capacity and research to track increasing drug resistance as it happens, over time. Our leaders and governors were also advised to ensure that use of antibiotics is strictly regulated, something that can only be achieved through cooperation between themselves and the pharmaceutical industry. If innovation in research were encouraged, and new tools developed, the WHO argued, the threat might yet be contained. But herein lies the biggest challenge of all. Antibiotic development has slowed down considerably over recent decades as the pharmaceutical industry becomes ever more governed by profit margins. Since they are used for a relatively short time, and are often effective in curing the patient, antibiotics are nowhere near as lucrative as the drugs that treat long-term disorders, such as diabetes or asthma. Because medicines for chronic conditions are so much more profitable, this is where pharmaceutical companies invest their time and money. A further stumbling block is the relatively low cost of antibiotics, newer examples of which tend to cost a maximum of £1,000 to £3,000 per course. When compared with cancer chemotherapy, for example, a process of treatment that costs tens of thousands of pounds, the discrepancy becomes impossible to mend.
As a race, humans have seen remarkable health benefits over the years as a huge number of illnesses have been treated by antibiotics, but we now face a global emergency as antibiotic-resistant bacteria are beginning to emerge more rapidly and frequently than ever before. Not only has this created a potential health crisis, since we are increasingly unable to provide the sick with treatment as a result of worldwide overuse of these drugs, but it is also unlikely to be tackled any time soon, as the powerful pharmaceutical companies are primarily driven by profit and see little benefit in researching and creating new antibiotics. It simply does not work on the balance sheet, and so it falls to governments and individuals around the world to find ways to manage the crisis. Coordinating such efforts will not be easy.
Bình luận